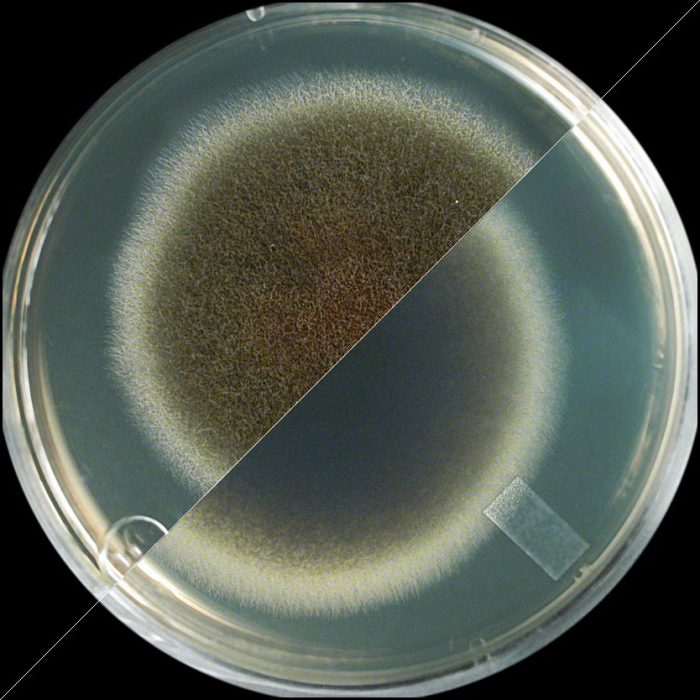
אולוקלדיום במבחנה
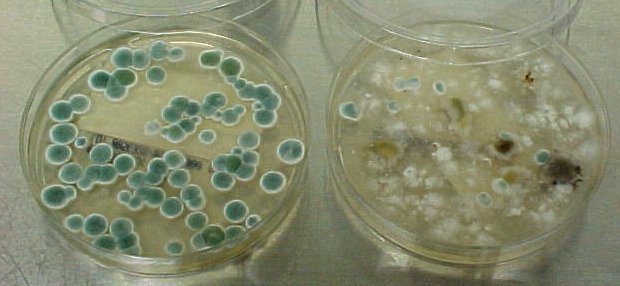
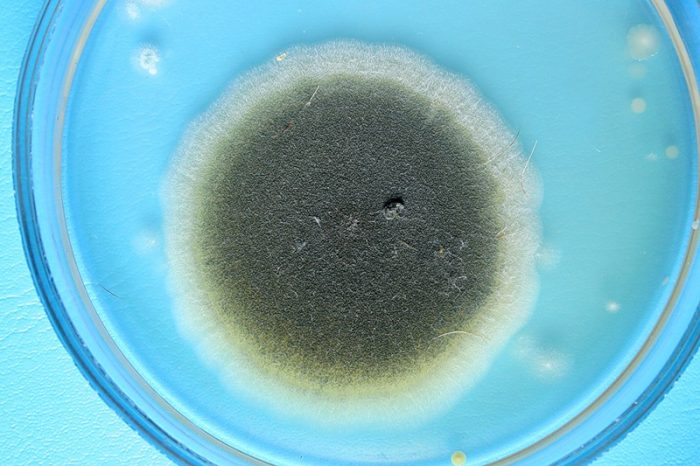
אספרגילוס במבחנה

כל אחד ראה עובש לפחות פעם אחת בחייו - באזורים לחים או על מזון ישן ומקולקל. יש לו ריח ייחודי, שחלק מהאנשים מוצאים מושך. וכך גם המראה שלו: עובש מגיע במגוון רחב של צבעים, גדלים ומרקמים, אך כמעט כל הסוגים מהווים סכנה בריאותית לבני אדם ולכל יצור חי אחר. עובש מתרבה באמצעות נבגים, אשר שוקעים ומשגשגים במהירות בסביבה לחה. וגוף האדם, מנקודת מבט זו, הוא מקום אידיאלי לנבגים לחיות ולהתרבות. עובש הוא טפיל שבעודו חי בגוף, מדלל אותו. כדי להימנע מסיכון, בסימן הראשון לעובש בדירה שלכם, עליכם להתחיל להילחם בו, ולבחור את התרופה היעילה ביותר ממגוון תרופות עממיות או כימיקלים ביתיים.
תוֹכֶן
סוגי עובש
פטריות עובש מיקרוסקופיות משגשגות באזורים עם לחות גבוהה ומתרבות באמצעות נבגים שעוברים מרחקים ארוכים עם זרמי אוויר וחודרים עמוק לתוך הגוף, החומר או המשטח שבו הן שוקעות.
נבגי עובש הם כה קטנים עד שהם יכולים לחדור בקלות לגוף האדם ולגרום למגוון בעיות, החל מדלקות עור ועד נזק לכליות ודימום פנימי. לכן, חיוני להימנע מאזורים בהם קיים עובש. אם הופיע עובש בביתכם, התקשרו למיקולוג כדי לזהות את סוג הפטרייה ולספק דוח, ולאחר מכן צרו קשר עם תחנת ההדברה הקרובה ביותר. למרבה הצער, לעתים קרובות אין זמן לחכות לבדיקה, לכן עליכם לפעול במהירות ולנסות להסיר את העובש בעצמכם. חשוב להבין שישנם סוגים רבים של עובש, וכל אחד מהם רגיש להתקפה בדרכו שלו.
עובש שחור
זני עובש שחור נבדלים זה מזה בצבע (למרות השם, הוא לא תמיד שחור), בשלב ההתפתחות ובבית הגידול, כלומר, בחומר עליו מין מסוים מתיישב:
- אולוקלדיום רגיש מאוד ללחות, ובנוסף לקירות ותקרות, תוקף מוצרי מזון.
- קלדוספוריום. בשלבו הראשוני, הוא חסר צבע לחלוטין, אך בהמשך יכול לקבל כל גוון. הוא שורד ומתרבה גם בטמפרטורות נמוכות, אינו דורש לחות, ומסוכן במיוחד לצמחים. הוא תוקף משטחים שונים וניזון מדלקים וחומרי סיכה.
- פנצליום. משמש ליישון גבינות עובש לבנות עדינות, אך נפוץ יותר למצוא אותן על קירות דירות ומוצרי מזון. מסוכן מאוד לבני אדם.
- אלטרנטריה. שחור בעיקר, אם כי נמצאים גם גוונים שונים של אפור. הוא גדל על צמחים, פירות וירקות ויכול גם להשפיע על העור ודרכי הנשימה של בני אדם.
- אספרגילוס. עובש לבן עם נבגים שחורים ייחודיים. הוא גורם לאספרגילוזיס, תגובה אלרגית מסוגים שונים. הוא גדל על קירות ותקרות.
- כאטומיום. עובש שחור שגדל על קירות ומוצרי מזון. זה גורם לאלרגיות, אבל מסוכן במיוחד כשהוא נכנס למערכת העיכול.דווח על מקרי מוות כתוצאה מהרעלה על ידי פטרייה זו.
- פומה. פטרייה שחורה או חומה עם נבגים חסרי צבע. היא תוקפת את עלי הצמח ואת פירותיו.
- וולמיה. סוג זה של עובש משגשג בלחות גבוהה ובטמפרטורות גבוהות, גדל על קירות ומחיצות, וקשה להסירו. הוא אינו גורם נזק לבני אדם.
יש להסיר עובש שחור מיד עם הבחנתו על קירות, תקרות, רצפות או משטחים אחרים בבית. יש לבצע את השלבים הבאים בעת הסרת עובש:
- לבשו כפפות, מסכה, משקפי מגן וסגרו את הדלתות והחלונות בחדר המטופל כדי למנוע מהפטרייה להתפשט ברחבי הדירה. הניחו שטיחון אטום על הרצפה.
- ראשית, בצעו טיפול מכני. הסירו כל טפט מעופש והשתמשו במרית כדי להסיר כל טיח מעופש.
- שטפו היטב את האזור בו הייתה הפטרייה באמצעות כימיקלים או תרופות עממיות.
- יבשו את החדר. עובש משגשג במקומות לחים, לכן יש לייבש היטב את האזור המטופל כדי למנוע היווצרות מושבות חדשות. מאוורר אינו מתאים למטרה זו - הוא רק יפיץ את הנבגים ברחבי החדר או הדירה.
- טפלו בקירות בחומרי חיטוי. עובש יכול להתפשט בכל החדר, אך לפתח צבע בולט רק באזור אחד (בהתאם לשלב ההתפתחות שלו). לכן, סילוק העובש במקום אחד אינו מבטיח שהחדר נקי מנבגיו. אם אתם מתכננים לשפץ את החדר (מכיוון שהסרתם את הטפט והטיח), מרחו שכבת פריימר המכילה חומר חיטוי על הקירות.
עובש לבן
עובש לבן אינו מדאיג בני אדם, מכיוון שהוא אינו נפוץ כמו עובש שחור וחי בעיקר על קירות, צמחים, אדמה ומוצרי מזון (לחם, פירות, פירות יער ואחרים).
עובש לבן מתבלבל לעיתים קרובות עם פריחה, שאינה מזיקה לחלוטין לבני אדם. כדי לגלות מה בדיוק גדל על הקיר שלכם, לבשו כפפות והסירו את ה"משהו" מהקיר. אם הוא מתפורר כמו גבישי מלח, זו פריחה. אם הוא יוצר שקעים בידיים שלכם, זו עובש, ויש לטפל בו.
כדי להיפטר מעובש על צמחים, אדמה וקירות, פשוט השקו את האזור הפגוע בחומצת לימון מדוללת (1-1.5 כפיות חומצה לכוס מים חמים) כל יומיים-שלושה. זנים רבים של עובש זה נהרגים, בעוד שחומרי חיטוי יעילים נגד אחרים.
עובש לבן אינו מזיק לבני אדם ואף גדל במיוחד על גבינות קממבר וברי.
כְּחוֹל
פטריית הכתם הכחול תוקפת את מבנה העץ, ומעניקה לו צבע כחול-אפור לא מושך. היא נמצאת לעתים קרובות על משטחי עץ וחודרת בקלות את שכבת הצבע, ויוצרת מעברים שדרכם מים יכולים לחלחל. היא מובילה להרס מבנה העץ, מפחיתה את בטיחות המבנה, וגם מובילה להופעת סוגים אחרים של עובש.
כדי לחסל פטריית כתמים כחולים, ניתן להשתמש בחומרי הלבנה מיוחדים לעץ, אשר מסירים ביעילות עובש מסוג זה ממשטחי עץ ואלמנטים.
תרופות לעובש
עובש הופיע על פני כדור הארץ הרבה לפני בעלי חיים ובני אדם. יש לו אינספור מינים, שלכל אחד מהם חולשות משלו. פותחו מוצרים רבים ושונים נגד עובש. חלקם "אוניברסליים", כלומר הם הרסניים לסוגים רבים (אך לא לכולם) של פטריות, בעוד שאחרים נועדו להרוג סוג ספציפי של עובש.
כימיקלים
חומרים כימיים הם היעילים ביותר נגד עובש שכבר הופיע בבית, מכיוון שמרכיביהם מסוגלים לחדור עמוק לתוך החומרים שבהם הנבגים שוקעים, לשחית את העובש, תוך גרימת נזק כמעט בלתי הפיך למבנה פני השטח של הפטרייה.
דומסטוס
דומסטוס מכיל אקונומיקה, האויב הגרוע ביותר של עובש שחור. רק תחשבו על התחושה שמקבלים הידיים שלכם אחרי כמה דקות של שימוש באקונומיקה בזמן ניקוי ללא כפפות. חומר זה פועל בדיוק באותו אופן על עובש, וכמעט ואינו משאיר לו סיכוי לשרוד. פשוט מרחו את המוצר על המשטח והשאירו אותו למשך 30-40 דקות, לאחר מכן שטפו במים חמים.
הקפידו להשתמש בכפפות בזמן העבודה! ייתכן שהתוצאה תהיה בקושי מורגשת בפעם הראשונה, לכן יש לחזור על ההליך לאחר שבוע.
דומסטוס משמש בעיקר להסרת עובש בין אריחים בחדרי אמבטיה ומטבחים, כמו גם סביב כיורים ומקלחונים. אינו מומלץ לשימוש על תקרות.
חיפשתי משהו קטלני נגד עובש שחור ועדין לאמייל של האמבטיה שלי. מצאתי את דומסטוס. ואני מרוצה בצורה מדהימה! אף מוצר אחר לא עבד כמוהו. אני אפילו לא חושבת על העובש במשך חודשיים-שלושה. אני ממליצה עליו בחום! חדר האמבטיה לבן נוצץ, והרובה והתפרים ללא רבב. ריח האקונומיקה חזק, אבל עדין יותר מסמייל ווייט. אז מה אם זה רעיל? זה זול, סמיך ויעיל כמו טורנדו! לא כדאי לבלות איתו יותר מדי זמן; ממש קשה לנשום, וצריך ללבוש כפפות. זה מאכל את העור והציפורניים כמו כל חומר ניקוי על בסיס כלור. אבל אם אתם צריכים פתרון דרסטי יותר להסרת עובש, לכלוך, חלודה, פלאק וכתמי יופי אחרים, דומסטוס הוא הפתרון הנכון.
פופים
חברת פופאס מייצרת מגוון מוצרים נגד עובש:
- עם ובלי כלור,
- נגד טחב,
- מפני פלאק ירוק ופטריות אחרות,
- אמצעים למניעת התפתחות עובש,
- אמצעים להסרה ישירה.
כל חומר יעיל למדי בתחום שלו (צבעים ומרק מונעים את הופעת הפטרייה, חומרי הדברה מסירים אותה), לכן יש צורך לבחור את המוצר הנכון על סמך השפעתו על מיקרואורגניזמים.
בעת עבודה עם מוצרים מסדרת Pufas, יש צורך ללבוש כפפות, במיוחד בעת עבודה עם מוצרים המכילים כלור. מוצרים אלה מתאימים להסרת עובש ממגוון רחב של משטחים בבית. אם הופיע עובש על הטפט, יש להסירו תחילה ולאחר מכן לטפל בקירות.
מקרה מצחיק התרחש בזכות דוחה העובש "קומטה" של PUFAS. ילדיי לומדים בבית ספר ישן מאוד (לא אציין את שמו כדי למנוע בלבול), וריח מעופש הופיע בכיתת בית הספר היסודי של בתי. המורה ביקשה מההורים עזרה להיפטר מהריח וממקור הבעיה. באותה תקופה עבדתי כיועצת מכירות בכירה בחנות לשיפוץ בית, והם בדיוק הגיעו עם "קומטה" (אני מנסה לבדוק את המוצרים האלה באופן אישי לפני שאני מוכרת אותם; אני לא יכולה למכור אותם לאנשים, אני לא יודעת מה הם מוכרים). אז הייתה לי הזדמנות גם לבדוק את המוצר וגם לעזור לבית הספר. הנה תיאור קצר של השלבים שלי: 1. לגרד את העובש; 2. למרוח את המוצר פעמיים, לפי ההוראות; 3. לצבוע את הקיר בצבע על בסיס מים. שנה לאחר מכן, מנהל בית הספר האשים אותי ואת המורה בבית הספר היסודי בהסרת העובש מהכיתה, וגרם לו להתפשט למסדרון. צחקנו על האשמה זו זמן רב. אבל כבר 3 שנים אין שום סימן לעובש בכיתה.
קרסיט
קרזיט הוא חומר אנטי-פטרייתי הנלחם ביעילות בעובש, חזזיות, טחב ומיקרואורגניזמים אחרים. הוא מיועד למשטחים מינרליים (לבנים, אבן, בטון, טיח). הוא לא רק הורג עובש קיים אלא גם מונע התפתחות של מושבות חדשות.
קרזיט הוא חומר ידידותי לסביבה שחודר עמוק לתוך החומר, שם הוא הורג פטריות. יש לדלל את המוצר במים (ביחס של 1:2). למשטח שטופל ב-Ceresit יש את המאפיין של צביעה בצבע שונה.
ניקיתי את הקיר ביסודיות. ריססתי אותו בנדיבות, לפי ההוראות, פעם אחת. בקבוק אחד כיסה שני מטרים רבועים. ואכן, אחרי שהתייבש, לא נותרו כתמים או פסים. קיר חלק ולבן. אפילו לא היה מה לצלם. אחר כך לקחתי הפסקה מהשיפוץ, והקיר עמד לא צבוע במשך כחודש. שלושה שבועות לאחר מכן, הופיע קצת עובש. חשדתי שיש לי נזילה בצינור איפשהו בתוך הקיר והזמנתי מומחה מחברה המתמחה בהסרת עובש מקירות בדירות ובמשרדים לייעוץ. הוא אמר לי שהצינורות תקינים, ושה-Ceresit CT99, שזכה להערכה רבה, הוא מסיר עובש חלש מאוד.
מלרוד
מוצרי מלרוד מסירים עובש ממשטחים כגון פלסטיק, אריחים וטיח. מוצרים אלה מנקים את פני השטח של עובש ומשמידים את הנבגים שלו בתוך החומר. מוצרי החברה משמשים בעיקר נגד עובש שחור, שקשה להסירו. מלרוד פיתחה תוסף מיוחד המונע הופעתו מחדש של עובש על משטחים שונים.
לפני שש שנים קנינו דירה ועשינו שיפוץ יסודי. אחרי ארבע שנים, עובש התחיל להופיע בכמה מקומות בחדר האמבטיה, ולא משנה מה ניסינו, הוא המשיך לחזור. יום אחד, בן דוד שלי המליץ על חומר ניקוי עובש של מלרוד. קניתי אותו וטיפלתי באריחי חדר האמבטיה באותו היום. העובש נעלם תוך דקות, אבל עדיין הייתי צריך לחכות את הזמן הנדרש ולשטוף היטב במים. העובש לא הופיע במשך שנתיים וחצי, והיום שמתי לב לכתם קטן. טיפלתי בו עם חומר ניקוי עובש של מלרוד ושכחתי ממנו שוב. מוצר זה לא פוגע באריחים; הצבע והברק נשארים שלמים (מוצרים קודמים הפכו את האריחים לנקבוביים והברק נעלם בכמה מקומות; הלוואי והייתי מגלה את זה מוקדם יותר). היו לי גם כתמים כהים שנוצרו בין השיש לכיור במטבח, וגם עם זה המוצר הזה עזר לי.
סאבו
סאבו מגיע בבקבוק ריסוס, מה שמקל מאוד על חיסול מיקרואורגניזמים מזיקים. ניתן להשתמש בו גם כדי למנוע צמיחת עובש, דבר שחשוב במיוחד למטבחים וחדרי אמבטיה.
למרות קלות השימוש, סאבו הוא מוצר עוצמתי מאוד אשר לרוב קוטל עובש ונבגים כבר מהמריחה הראשונה. אם העובש נרחב, יש לחזור על הטיפול לאחר מספר ימים, ולאחר מכן העובש ייעלם לחלוטין.
סאבו הוא מוצר יעיל מאוד, אך הוא מסוכן מאוד לגוף האדם, ולכן יש לאוורר היטב את החדרים בהם מתבצע הטיפול, ואסור שיהיו בהם מוצרי מזון פתוחים.
הספריי ממיס עובש תוך דקות! הוא נעלם ממש מול העיניים, כאילו הוא מתמוסס. התמונה מראה בבירור שגם עובש מושרש נעלם במהירות, ובתוך חצי שעה, לא נשאר זכר! לאחר מכן ניגבתי את האריחים והרובה עם כל ספריי שנותר, השארתי אותו למשך יום ופתחתי את חדר האמבטיה לאוורור. כששטפתי את האריחים עם חומר ניקוי מיוחד למחרת, הם נצצו נקיים והפכו לבנים משמעותית, במיוחד מורגש ברוחה:
סנז'
סנז' הוא חומר משמר עץ המיוצר באופן מקומי, שנועד להגן על עץ מפני כתמים כחולים וסוגים אחרים של עובש, כמו גם ריקבון ומחרקים שונים הניזונים מעץ. היתרון העיקרי של מוצר ידידותי לסביבה זה הוא שקשה מאוד לשטוף אותו - החומר חודר לעץ ונקשר עם סיבי העץ.
סנז' משפר את חוזק העץ, אך משנה מעט את צבעו לירוק בהיר. למרות הקשר החזק של המוצר למבנה העץ, הדבר אינו מפריע ליכולתו של המבנה הכללי לנשום.
השתמשנו במוצר הזה לטיפול בריצוף מהוקצע. הבית שלנו ישן, וכשהנחנו את החזית ובודדנו את הרצפה, החלטנו להחליף את הריצוף. לשם כך, הוקצענו את הקרשים כנדרש והנחנו אותם לייבוש במשך שישה חודשים. מיד לפני הנחת הקרשים החדשים, טיפלתי בכל לוח בחומר משמר Senezh. למרות שעל התווית מצוין שהמוצר מיועד לתנאים "קשים", למרבה המזל, התנאים שלנו היו רחוקים מאלה. הקרשים והקורות טופלו מראש, חלל הזחילה שלנו תמיד יבש, ומעולם לא חווינו תנודות טמפרטורה. לכן, העבודה היחידה שעושה החומר המשמר במקרה שלנו היא הגנה מפני חרקים קודחים בעץ, ונראה ש-Senezh עושה את העבודה הזו עד כה. לפחות הרצפה עדיין במקומה ולא שקעה. עם זאת, מה ש-Senezh בהחלט לא יכול להתמודד עם לחות, מה שאושר שוב ושוב מניסיון. יש לנו מדפי מתכת במרתף שלנו, ועליהם לוחות עץ בגודל 40 על 15 ס"מ כל אחד. הכל מטופל מראש בחומר חיטוי. טיפול זה מחזיק מעמד שתי עונות. לאחר מכן, הכל מתפרק. טוב שהבעיה הזו מתגלה מוקדם באביב. אפילו עם אוורור טוב, אי אפשר להיפטר מהלחות, וקיווינו ל"סנז'", אבל אבוי... למרות שאני חוזר ואומר, התווית טוענת להגנה מוחלטת.
כַּדוּר שֶׁלֶג
סנז'קה משמשת למאבק בעובש ולמניעת הופעתו. היא משמשת בעיקר על משטחים מינרליים, שם החומר חודר לעומק ונשאר שם, מבלי להפריע ליישום חומרי בניין אחרים. סנז'קה הורסת עובש קיים ומונעת צמיחה חדשה.
המוצר בטוח לחלוטין לבריאות האדם ומשמש אך ורק במהלך תיקונים לפני מריחת צבעי יסוד, צבעים ולכות.
העניין הוא שאני מתכונן לשיפוץ אמבטיה גדול כבר כמה חודשים. לא נתתי לטחב בחדר האמבטיה הזדמנות להשתלט. אז, כדי להתחיל, הייתי צריך לפתוח במתקפה מלאה על הטחב. ניסינו שיטות שונות. ועכשיו, אחרי חודשיים, סוף סוף ראיתי תוצאות. השתמשנו במוצר הזה בדיוק לפי ההוראות. קירות חדר האמבטיה החזיקו מעמד כבר חודשיים אחרי שטיפלנו בהם. אני חושב שעכשיו אנחנו בהחלט יכולים להתחיל את השיפוץ! לדעתי, המוצר הזה הצליח להילחם בטחב, אז אני שמח להמליץ לכם עליו!
ניאומיד
ניאומיד משמש להשמדת עובש קיים ולמניעת התפשטות חדשה. היצרן מתחייב לתכונות המגן של המוצר למשך 25 שנים.
מומלץ להשתמש במוצר מיד לפני מריחת צבע, טפטים, אריחים וסוגים אחרים של ציפויים על קירות, רצפות ותקרות.
רכשנו את מוצר "NEOMID Mold Protection". קנינו כמה בקבוקים והתחלנו לטפל בכל המשטחים שנפגעו מעובש וטחב. מרחנו אותו ממש על הכל: קירות מתחת לטפט, קירות מתחת לאריחים, קירות מתחת לצבע ורצפות. טיפלתי גם בכל הארונות כי העובש כבר היה על הבגדים והנעליים שלי. מרחנו אותו כפי שהומלץ על גב הבקבוק: ממרחק של 10-20 ס"מ, ריססנו אותו על כל המשטחים, ואז צחצחנו אותו לאחר שעתיים, הסרנו את העובש והטחב, ומרחנו שוב. לבשנו כפפות. אחר כך יצאנו מהבית כי הריח היה חריף ולא נעים. השתמשנו בכמה בקבוקים של 0.5 ליטר, ולא חסכנו, מרחנו אותו בנדיבות. מה אני יכול לומר: לפחות באזורים הנראים לעין - ארונות, אדני חלונות ותקרת חדר האמבטיה - העובש לא הופיע שוב. היצרן מבטיח הגנה עד 12 שנים. כמו שאומרים, הזמן יגיד!
שיאולטה
ההרכב חודר עמוק לתוך חומרים (עץ, לבנים, משטחי אבן), ומשמיד נבגי עובש. הוא אינו משמש כאמצעי מניעה נגד התפתחות פטריות. יש למרוח את Xiolate במהלך עבודות בנייה או שיפוץ לפני מריחת סוגים שונים של ציפויים.
גלריית תמונות: כימיקלים ביתיים נגד פטריות
- ניתן להשתמש בדומסטוס להסרת עובש אפילו במכונת כביסה.
- קומט, מוצר של היצרן פופס, מסיר עובש בצורה מושלמת כבר בפעם הראשונה.
- יש לדלל את קרזיט תמיד במים.
- מלרוד הוא מסיר עובש בטוח
- מרסס סאבו קל מאוד לשימוש.
- סנז' נמכר במיכלים גדולים לנוחות השימוש.
- סוכן אנטי-פטרייתי אוקראיני סנז'קה מתמודד היטב עם סוגים שונים של עובש.
- ניאומיד נמכר הן במיכלים גדולים והן במיכלים קטנים.
אלפא טכנולוגיה
חברת אלפא-קסנון פיתחה מערכת פעימה מיוחדת המשתמשת באור אולטרה סגול כדי להשפיע על מיקרואורגניזמים הנמצאים בחדר ברמה המולקולרית.
הציוד מוגדר באופן אינדיבידואלי לכל חדר, מה שמבטיח סטריליות מוחלטת. המערכת פולטת גלי אולטרה סגול קצרים ועוצמתיים ההורגים מיקרואורגניזמים. המכשיר פועל במהירות רבה: עבור חדר של 100 מ"ר.2 מספיק להפעיל את המכשיר למשך 3 דקות. אסור שיהיו אנשים או בעלי חיים בחדר בזמן שהמכשיר פועל.
אלפא היא טכנולוגיה יקרה מאוד ויעילה ביותר, שכן היא הורגת אפילו זני HIV וגם מסלקת ריחות עשן ועשן מתמשכים. היא משמשת בעיקר בסביבות תעשייתיות. עם זאת, בחירת חברה שיכולה לחטא מקומות באמצעות טכנולוגיית אלפא באזורכם צריכה להיעשות בזהירות, תוך הסתמכות על ביקורות והמלצות מחברים. הונאה ושירות גרוע הם לעיתים שכיחים.
דירת הוריי הוצפה על ידי השכנים בקומה העליונה, אז אמי שכרה חברה בשם Method Alpha להסרת עובש וטחב. הצוות הגיע באיחור, וכולם היו בפעילות סוערת, ואמרו לנו שזה לא משהו מיוחד ושאנחנו לא הראשונים לסבול את הגורל הזה. הם עשו את זה כאילו הם עושים עבודה טובה, וזו הייתה פשוט חווית למידה. אפילו לא באמת ראינו מה הם עושים, כי הם אמרו לנו להיכנס למטבח כי היה מסוכן להיות באזורים המטופלים (יש לי ילד קטן). אחרי הביקור הראשון של הצוות, למשפחה שלנו היה רושם חיובי על החברה, אבל כפי שהתברר מאוחר יותר, זה היה מטעה. אחרי כל הטיפולים שסיפקה החברה הזו, ביצענו שיפוץ שני, אבל רק חודש וחצי לאחר מכן, העובש חזר. עדיין לא הצלחנו לקבל הסברים ברורים מהנהלת החברה הזו. הם לא החזירו לנו כסף על השירות שסיפקו, והם לא ניסו לתקן את הליקויים בעבודתם, למרות שיש לנו אחריות לשנה במסגרת החוזה.
שיטות מסורתיות
בנוסף לטיפולים כימיים, תרופות עממיות, שהן בטוחות משמעותית לגוף האדם, יעילות גם הן במאבק בעובש. אלה כוללות את השיטות הבאות:
- אלכוהול - מסיר ביעילות עובש מאזור קטן, אפילו עובש שחור, אך בכמויות קטנות, הורג נבגים בעומק רדוד;
- חומץ - משמיד כ-80% ממיני העובש הנמצאים בבתים, אך יש להשתמש בו ללא דילול: יש לרסס על האזור המזוהם ולהשאיר למשך 10-12 שעות, לאחר מכן לנגב את המשטח במטלית רטובה;
- מי חמצן הוא חומר אנטיבקטריאלי שניתן להשתמש בו נגד פטריות: הוא מסיר היטב כתמי עובש כהים בשל אפקט ההלבנה שלו;
- סודה לשתייה היא אחת מחומרי הניקוי הביתיים הטובים ביותר: בזכות המרקם שלה, היא סופגת במהירות עודפי לחות, אינה חודרת לחומר, ולכן אינה הורגת נבגים;
- אקונומיקה עם כלור - משמשת על שטחים מזוהמים גדולים למדי, חודרת עמוק לתוך החומר, הורסת נבגים בפנים, מנקה את המשטח מבחוץ ומלבינה כתמים כהים מהפטרייה, אך יעילה רק על משטחים חלקים;
- שמנים ארומטיים (ורד, עץ התה, ערער ואחרים) הם חלק מחומרי האנטי-עובש הידידותיים ביותר לסביבה ויעילים למדי: הם הורגים פטריות ויכולים להלבין את פני השטח לאחר מכן;
- סבון כביסה (72%) - הוא מכיל כמות גדולה של אלקלי, אשר הורסת את מבנה הפטרייה: נגב את המשטח הנגוע בספוג סבוני והשאיר למשך שעה או שעתיים, ולאחר מכן שטוף במים חמים;
- פריימר - אינו הורג עובש קיים, אך מונע את הופעתם של מיקרואורגניזמים חדשים, לכן יש להשתמש בו רק על משטחים נקיים שבהם אין פטרייה;
- צבע - כמו פריימר, הוא אינו הורג עובש, אלא רק מונע את הופעתו: יש למרוח אותו על משטח שנוקה בעבר מעובש;
- פורצילין הוא חומר אנטי-פטרייתי טוב שישמיד אפילו נבגים בעומק: טחנו היטב 10 טבליות לאבקה והמיסו אותן במים בטמפרטורת החדר, נגבו את המשטחים הנגועים בנוזל זה, בעזרת כפפות, אין צורך לשטוף לאחר מכן;
- כלורהקסידין הוא מוצר שנוי במחלוקת: למרות שהוא מכיל כלור, שמפחיד נורא מפטריות, הוא יכול לגרום לצמיחה של מושבות של סוגים מסוימים של עובש, ולכן השימוש בו אינו מומלץ;
- תמיסת אשלגן פרמנגנט - הורסת עובש ונבגים עמוקים: יש להמיס כפית של אשלגן פרמנגנט בליטר מים ולרסס את כל המשטח הפגוע בתמיסה זו;
- לימון - החומצה הכלולה בפרי זה הורסת פטריות, חודרת עמוק לתוך החומר ומסלקת נבגים, ומלבינה היטב את המשטחים: כדי להיפטר מעובש, פשוט רססו מיץ לימון על המשטח הפגום.
גלריית תמונות: תרופות עממיות לבקרת עובש
- הפריימר אינו הורג עובש קיים, אך הוא מונע את הופעתו מחדש.
- מיץ לימון טוב למאבק בעובש ולהלבנת משטחים.
- תמיסה של אשלגן פרמנגנט הורסת עובש ונבגים עמוקים
- שמן עץ התה הוא תרופה ידידותית לסביבה נגד עובש.
- סבון כביסה מכיל אלקלי, אשר הורס את מבנה הפטרייה.
- אקונומיקה עם כלור יעילה רק על משטחים חלקים.
- סודה לשתייה טובה בהסרת כתמים ובמלחמה בחיידקים.
- אלכוהול אתילי יכול אפילו להרוג עובש שחור.
- חומץ הורג כ-80% ממיני העובש.
- פורצילין הוא חומר אנטי-פטרייתי תרופתי
היה כתם עובש על התקרה אחרי נזילה. הוספתי גופרת נחושת לטייח. אמרו גם שאפשר לשטוף אותו עם מי חמצן או סודה לשתייה. בעיקרון, עובש מפחד מסביבות אלקליות.
מנורת אולטרה סגול
אור אולטרה סגול הורס מספר רב של פטריות וחיידקים. עובש הוא מיקרואורגניזם עמיד למדי, ולכן הוא דורש חשיפה ממושכת לאור אולטרה סגול.
לשימוש ביתי, מנורות קוטלות חיידקים מבוססות כספית הן הטובות ביותר. כספית זוהרת תחת השפעת חשמל בתחום האולטרה סגול, ומספקת את אפקט החיטוי היעיל ביותר. קרינה זו משמידה את כל החיידקים והפטריות, כולל נבגי עובש, אפילו אלה הנמצאים עמוק בתוך הקיר. בנוסף, נוצר אוזון, אשר גם הוא משמיד פטריות שאור אולטרה סגול אינו הורג.
לשימוש ביתי, יש להדליק את המנורה למשך מספר שעות. אסור שיהיה אף אחד בחדר, שכן קרינה אולטרה סגולה עלולה לפגוע בתאים בגופם של אנשים ובעלי חיים. לאחר מכן, החדר יהיה סטרילי לחלוטין, אך יש צורך לאוורר אותו כדי להסיר כל ריחות לא נעימים. השתמשו במנורת האולטרה סגולה רק כאשר מופיע עובש; אין צורך להשתמש בה שלא לצורך.
תמיד חלמתי על מנורת אולטרה סגולה. היא מצוינת בחיטוי האוויר. הבעיה הזו החמירה במיוחד כשנולד לנו תינוק. כמו כן, כמעט ולא אווררנו את החדר, מחשש שהתינוק יתקרר בחורף. אוורור לקוי גרם להתערפלות החלונות, מה שהוביל לצמיחת עובש. גם הטפט התחיל לגדול עובש, שהוא אלרגן חזק מאוד. קראתי באינטרנט על מוצרים כימיים רבים נגד עובש לדירות, אבל כולם היו רעילים והריחו רע. בחרתי ב"בליזנה" רגילה ובמנורת UV. ראשית, הרסנו את הטפט המעופש, טיפלנו בו ב"בליזנה" (אקונומיקה), ואז הדלקנו את מנורת ה-UV כשיצאנו לטיולים. ההוראות אומרות להשאיר את המנורה דולקת במשך תשע שעות כדי להרוג את העובש. לא היה לנו את הפריבילגיה הזו. אבל שעתיים-שלוש של חשיפה יומית נפטרו מהעובש בדירה שלנו.
עובש הוא גורם מסוכן שיש לחסל. קל מאוד לפתח אסטמה, וזה לא הדבר הגרוע ביותר שפטרייה יכולה לעשות לבעל בית. בסימן הראשון לעובש, אל תדחו את הטיפול באזור והשתמשו במוצרים שונים. אם אחד לא עובד, רכשו מיד אחר ונסו שוב. עדיף לנסות תחילה תרופות עממיות - הן יעילות, בטוחות לבני אדם ויחסית זולות. אם הן לא עובדות, השתמשו בכל אחד מהכימיקלים שהוזכרו לעיל, אך זכרו להגן על הידיים, דרכי הנשימה והעיניים.